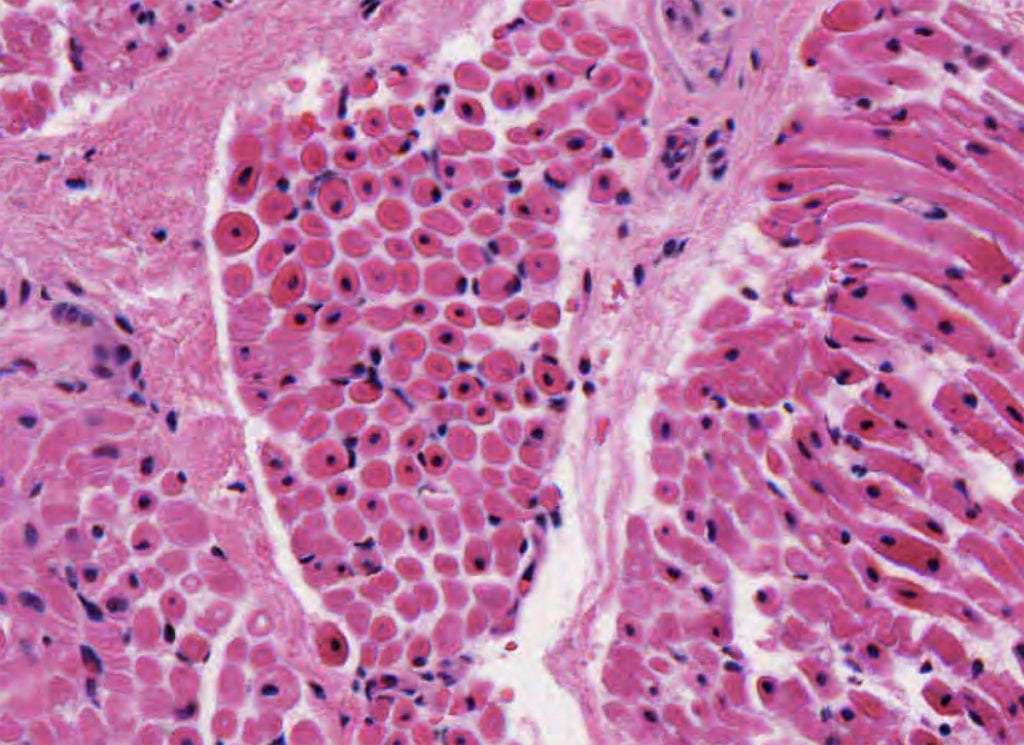

The disease associated with this classic pathology finding.

What is Duchenne Muscular Dystrophy?
This prolongs ambulation and is a staple of treatment for Duchenne Muscular Dystrophy.
Corticosteroids
This condition is associated with SCN4A (voltage-gated sodium channel) gene mutations and episodic weakness lasting minutes to hours.
What is hyperkalemic periodic paralysis?
A child presents with hypotonia, muscle weakness, delayed motor skills. As he ages, slowly progress and starts to get scoliosis, joint contractures, pectus excavatum (sunken chest). CK is normal. Trichrome studies show rod-like inclusions. EMG is normal. Diagnosis?
What is Nemaline Myopathy?

This medication, when combined with a statin, has a 32% incidence of myotoxicity.
What is cyclosporine?
The disease associated with this classic pathologic finding.

What is Inclusion Body Myositis?
These two classes of medications can treat myotonia.
Sodium channel blockers (mexiletine, phenytoin, and carbamazepine) and tricyclic antidepressants (amitriptyline, clomipramine, and imipramine)
This protein is affected in Duchenne Muscular Dystrophy.
A patient with ”failure to wean” off vent, flaccid limbs, reduced reflexes. CNs intact. EMG/NCS shows reduced CMAP amplitudes with prolonged duration, normal SNAPs, decreased muscle activity on direct stimulation.
What is critical illness myopathy?
Patients with diseases associated with this receptor are particularly susceptible to malignant hyperthermia when given succinylcholine and halothanes.
What is the Ryanodine Receptor? (half-points for central core disease)
The disease associated with this classic pathology finding. 
What is Central Core Disease?
This is the known curative treatment for Inclusion Body Myositis.
What is Nothing!
You cannot cure IBM.
Mutations in MT-TL1 are associated with this mitochondrial myopathic syndrome.
MELAS (mitochondrial encephalopathy, lactic acidosis, and stroke-like episodes).
A 74-year-old male presents with slow symptom progression of asymmetric proximal leg extensor and distal arm flexor weakness. CK is mildly elevated. What is the most likely diagnosis?
What is Inclusion Body Myositis?
A 45-year-old man is intubated and sedated for 4 days following a heart transplant for end-stage heart failure. Medications include high-dose corticosteroids, tacrolimus, ciprofloxacin, propofol, and pravastatin. Upon extubation, he is unable to lift his head, arms, or legs off the bed. Tendon reflexes are normal. Serum creatine kinase is 300 IU/L (normal =<200 IU/L). Sensory nerve conduction studies are normal. Motor nerve conduction responses are absent. Direct muscle stimulation does not produce a muscle action potential. Which of the following medications conveys the highest risk for this disorder?
What are corticosteroids?
The inheritance pattern associated with this disease.

Mitochondrial (because it's mitochondrial myopathy; ragged red fibers).
The therapy for the disease associated with this pathology, presenting as organomegaly with hypotonicity in infancy.
What is enzyme Replacement Therapy with intravenous alglucosidase alfa. (This is Pompe disease)
Dysferlin (DYSF) mutations are associated with this type of muscular dystrophy.
What is limb-girdle muscular dystrophy?
A patient has a hard time going to the gym because it causes his muscles to burn and cramp. Sometimes, he even has myoglobinuria and rhabdomyolysis afterwards and has to go to the hospital for IV fluids. CK is elevated. EMG is normal.
Forearm testing is performed and shows a 3x rise in ammonia but no rise in lactate or pyruvate.
What is a glycogen storage disease (McArdle's disease)?
A 65-year-old man with a past medical history of hyperlipidemia on atorvastatin presents with progressive proximal muscle weakness over 6 months. Examination shows symmetric proximal weakness of the upper and lower extremities. Laboratory studies reveal a creatine kinase of 8,500 U/L. Muscle biopsy shows scattered deteriorating muscle fibers with minimal inflammatory infiltrate. Which of the following is the most likely diagnosis?
What is Statin-induced necrotizing myopathy?
The disease associated with this pathologic image.
What is Centronuclear Myopathy?
This is an antisense oligomer medication for patients with Duchenne Muscular Dystrophy with out-of-frame mutations at exon 51, working by exon skipping the mRNA to put it back in frame.
What is Eteplirsen?
A 6-month-old infant presents with concerned parents. They have noticed the child is not lifting his head or rolling over. Upon evaluation, the child is noted to be hypotonic, significantly weak, and developing early signs of joint contractures. An MRI of the brain reveals significant cerebral dysgenesis. Which of the following defective proteins is most likely responsible for the infant's disorder?
What is Fukutin?
A 37-year-old woman who presents with progressive ptosis has had partial deafness since childhood and had a syncopal episode due to second-degree heart block last year. Examination reveals bilateral ptosis, complete ophthalmoplegia, retinal pigmentary changes, and bilateral sensorineural hearing loss. An MRI scan reveals mild cerebellar atrophy. Which of the following is the most likely diagnosis?
What is Kearns-Sayre syndrome (KSS)?
This HIV drug can cause mitochondrial myopathy.
What is Zidovudine?